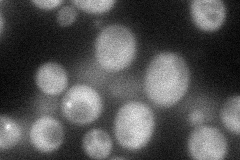
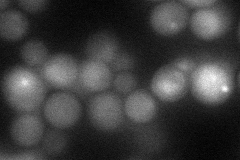
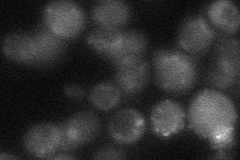

View description
Protein ser/thr kinase required for vesicle formation in autophagy and the cytoplasm-to-vacuole targeting (Cvt) pathway; structurally required for phagophore assembly site formation; during autophagy forms a complex with Atg13p and Atg17p
Localization:
Intensity:
Fold change:
Significance:
-
C’ GFP library in SD

below threshold16.36 -
N' NOP1pr-GFP in SD
cytosol48.1528 -
N' TEF2pr-mCherry in SD
cytosol,vacuole44.0159 -
N' NATIVEpr-GFP in SD
below threshold19.8127 -
N' TEF2pr-VC and Cyto-VN in SD

cytosol34.2616 -
C’ GFP library in SD+DTT

cytosol15.970.97No -
C’ GFP library in SD+H2O2

cytosol17.511.06No -
C’ GFP library in Starvation Media

cytosol14.740.9No -
C’ GFP library on the background of Pup2-DaMP

below threshold -
C’ GFP library on the background of CCT mutant

below threshold16.4551.00525No
